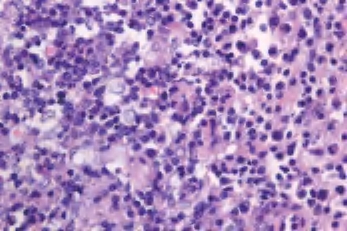
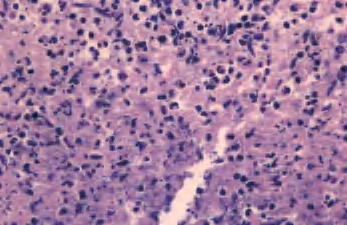

由于微生物及其毒性产物、细胞碎片或异物进入人体而激起淋巴结的反应。临床上可表现为淋巴结肿大,伴有疼痛和触痛,表面皮肤红肿。
1.肉眼观察 淋巴结肿大,充血水肿,包膜紧张,切面灰红色。
2.镜下 可见滤泡增生,生发中心扩大,含有大量核分裂像,窦组织细胞增生,窦内及实质内多数中性粒细胞浸润,可有坏死及脓肿形成。急性炎症慢性化后,则表现为滤泡、副皮质区及淋巴窦三者某一部分增生,炎细胞浸润减少并出现纤维化(图3-4、图3-5)。

图3-4 化脓性淋巴结炎
图3-5 化脓性淋巴结炎
由于摄入污染的水和食物感染沙门氏菌后引起。由于有众多的血清型,可导致不同的临床表现:伤寒、副伤寒、“沙门菌食物中毒”(急性胃肠炎)、局部脓肿菌血症及慢性带菌状态。
镜下 可见肠系膜淋巴结常常严重累及,淋巴结实质内胞浆丰富的伤寒细胞单个存在,弥漫分布或形成小结节。还可见大量浆细胞浸润及小灶坏死(图3-6至图3-9)。

图3-6 淋巴结伤寒

图3-7 肠伤寒

图3-8 伤寒结节

图3-9 伤寒细胞
多有猫或狗抓伤史。损伤后约数天或2~3个月后发病,发病部位因损伤部位而异,主要累及滑车神经、腋下及颈部。
1.肉眼观察 可见淋巴结肿大,可达鸡蛋至苹果大小;切面包膜增厚,可见脓肿。
2.镜下 呈现一种特殊的肉芽肿性炎,其特点为:①肉芽肿形成呈“星芒状”“口唇样”或“裂隙样”,而不像结核的“地图样”;②肉芽肿的构造:中间为急性炎,周围为慢性炎,病变外区域呈非特异性炎。淋巴滤泡反应性增生,多灶性中性粒细胞浸润,并形成星形脓肿,脓肿周围由上皮样细胞栅栏状排列,可见郎罕巨细胞,形成典型的中心化脓性肉芽肿(图3-10至图3-12)。

图3-10 猫抓病

图3-11 猫抓病,裂隙样坏死
图3-12 猫抓病,可见大量核碎片